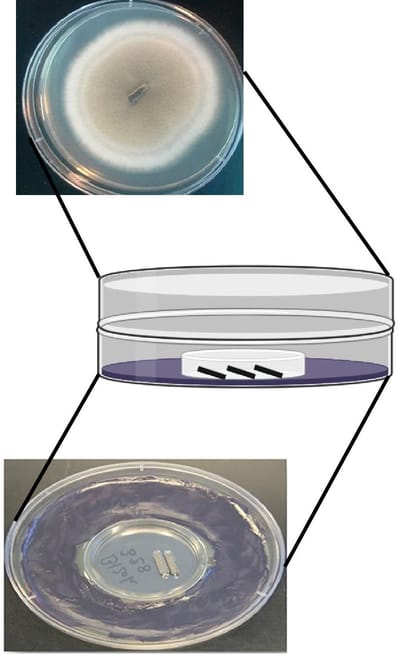
Bioactivity and emergent properties in microbial volatilomes

Research Projects #fungi
The application of comprehensive two-dimensional gas chromatography (GCxGC) to microbial volatile metabolomes has revealed stunning chemical diversity.
Read MoreMicrobes can smell each other and change their behavior based on which collaborators or competitors they sense in their environment.
Read More